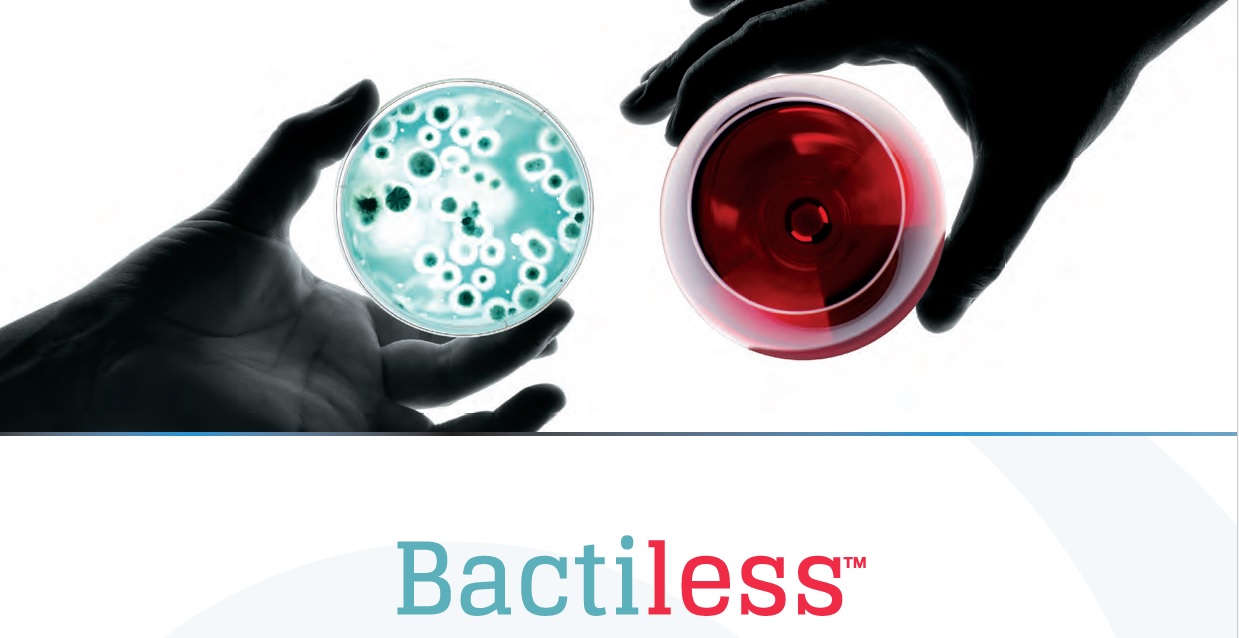
Product offering image

Berba grožđa – najvažniji trenutak u sezoni
Berba grožđa jedan je od ključnih trenutaka u vinogradarskoj godini jer upravo tada kvaliteta grožđa određuje buduću kvalitetu vina. Važno je odabrati pravi trenutak berbe kako bi odnos šećera, kiselina i aroma bio optimalan. Berba se najčešće obavlja rano ujutro kada su temperature niže, a grožđe svježije. Tijekom berbe važno je koristiti kvalitetan i pouzdan […]